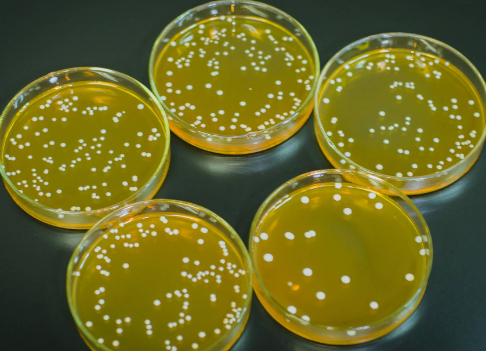

细胞培养过程污染现象解决方案参考
细胞培养中,细胞间交叉污染并不罕见,多是由于在培养中操作时各种细胞同时进行,混杂使用器皿和液体所致,这种污染能使细胞的生长特性、形态特征等发生变化,有些变化较轻、不易察觉,有些可能由于污染的细胞具有生长优势最终压过原来细胞而导致细胞的生长抑制,最终死亡。常用观察细胞形态学、分析生长特性和核型、检测细胞的标记物等方法检测交叉污染的细胞。细胞培养过程污染现象解决方案参考:
1、从物品、用品消毒灭菌着手
细胞培养所用物品清洗、消毒要彻底,各种溶液灭菌除菌要仔细,并在取样检菌一周后确认无菌才能使用。同时,在无菌过滤操作中,随着滤过体积的增大,滤膜破损的可能性增加,故应选择最后过滤的液体进行检测。定期对二氧化碳培养箱进行消毒。具体操作:75%的酒精搽拭培养箱后,使用可移动的紫外灯至少消毒30min,加入高压灭菌过的超纯水于培养箱水槽中保持湿度。也可配制300ml的饱和硫酸铜加3L灭菌超纯水混合成硫酸铜溶液加入水槽中。
2、添加抗生素
各种抗生素性质不同,对各种微生物的作用也不同,联合应用比单用效果好,预防性应用比污染后使用好。但反复使用抗生素会使微生物产生耐药性,且对细胞本身也有一定影响,因此为避免诱导抗药细菌,应定期更换培养系统中的抗生素,或尽可能不用抗生素处理。
3、从操作者做起
(1)、进无菌室前要彻底洗手,按规定穿隔离衣。开始操作前要用75%酒精棉球擦手、擦瓶口和烧灼瓶口。
(2)、操作者动作要轻,安装吸管帽、打开或封闭瓶口等操作应在火焰近处并经过烧灼进行。但要注意,金属器械不能在火焰中长时间烧灼,以防退火;烧过的器械要冷却后才能使用;已吸过培养液的吸管不能再用火焰烧灼,因残留在吸管内的培养液成分如蛋白质等烧焦后会产生有害物质,吸管再用时会将其带到培养液中;胶塞、橡皮乳头及塑料的细胞培养用品过火焰是也不能时间太长,以免烧焦产生有毒气体,危害培养细胞,同时塑料细胞培养用品也会产生变形影响使用。
(3)、操作时尽量不要谈话,咳嗽以防止来自唾沫和呼出的气流所造成的污染。
(4)、使用培养液前不宜过早开瓶,开瓶后的培养液应保持斜位,避免直立,以防止下落细菌的污染。不再使用的培养液应立即封闭瓶口,培养的细胞在处理之前勿过早暴露在空气中。
(5)、操作完毕后应整理好工作台面,用消毒水浸泡的纱布擦拭台面。
(6)、吸取培养液、细胞悬液时,应专管专用,一旦发现吸管口接触了手和其他污染物品应弃去,以防止污染扩大或造成培养物之间的交叉污染。
4、防止细胞交叉污染
所有从别处转来的或是自己所建的细胞系都要早期留有的充足的冻存储备,一旦怀疑发生交叉污染,可做细胞遗传学方面的鉴定,如发现原有的细胞遗传物发生改变,可以复苏早期冻存的细胞使用。重要细胞系(株)的传代工作应由两人独立进行。
5、无菌室的彻底消毒
1)、新洁尔灭全面彻底擦洗无菌室。使用前应稀释即配即用。新洁尔灭和酒精相比,最大的优点是便宜,因为新洁尔灭500ml只需5元,而且可以稀释50倍用,而同样量的酒精价格可能是新洁尔灭的几十倍。
2)、甲醛熏蒸法:甲醛是一种广谱灭菌剂菌,其水溶液和气体对各种细菌、芽孢及真菌等微生物均有杀灭作用。甲醛价廉,熏蒸消毒时不损坏衣服、家具、皮革、橡胶等。市售的甲醛水溶液中一般含37-40%的甲醛。
其主要用法 :
a)、熏蒸消毒:每立方米空间甲醛用量为10~15毫升,熏蒸消毒时应密闭门窗封闭至少4h以上。高锰/酸钾加40%甲醛(1:1)混合后放入一开发容器中,立即可见白色甲醛烟雾。消毒后可放入25%氨/水蒸发中和刺激气味。氨/水用量为所用甲醛水溶液的一半,时间为30分钟。甲醛气体毒性非常强,所以操作时一定需带上防毒面具。
b)、自然挥发:将较大量的甲醛水溶液放入一敞开容器中,室内温度保持在18摄氏度以上,同时室内喷水以保持相对湿度在70%以上,经16小时可达到室内消毒的目的


